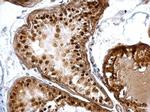
DUSP16 Antibody in Immunohistochemistry (Paraffin) (IHC (P))

Search
Invitrogen
DUSP16 Polyclonal Antibody
{{$productOrderCtrl.translations['antibody.pdp.commerceCard.promotion.promotions']}}
{{$productOrderCtrl.translations['antibody.pdp.commerceCard.promotion.viewpromo']}}
{{$productOrderCtrl.translations['antibody.pdp.commerceCard.promotion.promocode']}}: {{promo.promoCode}} {{promo.promoTitle}} {{promo.promoDescription}}. {{$productOrderCtrl.translations['antibody.pdp.commerceCard.promotion.learnmore']}}
产品信息
PA5-29888
宿主/亚型
分类
类型
抗原
偶联物
形式
浓度
规格
保存条件
运输条件
RRID
产品详细信息
Recommended positive controls: 293T, A431, H1299, HeLa, HepG2, Molt-4, Raji.
Predicted reactivity: Mouse (92%), Rat (92%).
Store product as a concentrated solution. Centrifuge briefly prior to opening the vial.
靶标信息
Dual-specificity phosphatases constitute a large heterogeneous subgroup of the type I cysteine-based protein-tyrosine phosphatase superfamily. DUSPs are characterized by their ability to dephosphorylate both tyrosine and serine/threonine residues. DUSP16 belongs to a class of DUSPs, designated MKPs, that dephosphorylate MAPK proteins ERK, JNK, and p38 with specificity distinct from that of individual MKP proteins. MKPs contain a highly conserved C-terminal catalytic domain and an N-terminal Cdc25-like domain. MAPK activation cascades mediate various physiologic processes, including cellular proliferation, apoptosis, differentiation, and stress responses.
⚠WARNING: This product can expose you to chemicals including mercury, which is known to the State of California to cause birth defects or other reproductive harm. For more information go to www.P65Warnings.ca.gov.
仅用于科研。不用于诊断过程。未经明确授权不得转售。